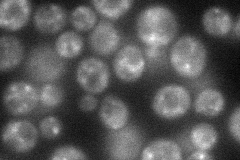
YJR031C
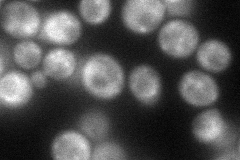
YJR031C
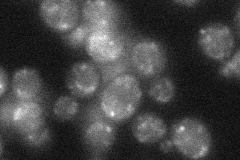
YJR031C
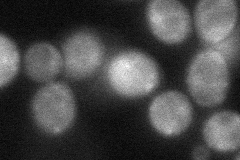
YJR031C
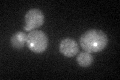
YJR031C
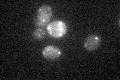
YJR031C

View description
Guanine nucleotide exchange factor for ADP ribosylation factors (ARFs), involved in vesicular transport between the Golgi and ER, Golgi organization, and actin cytoskeleton organization; similar to but not functionally redundant with Gea2p
Localization:
Intensity:
Fold change:
Significance:
-
C’ GFP library in SD

punctate29.87 -
N' NOP1pr-GFP in SD
punctate67.9467 -
N' TEF2pr-mCherry in SD
punctate66.1387 -
N' NATIVEpr-GFP in SD
punctate31.9962 -
N' TEF2pr-VC and Cyto-VN in SD
cytosol,punctate44.9186 -
C’ GFP library in SD+DTT
punctate23.910.8No -
C’ GFP library in SD+H2O2

punctate32.121.07No -
C’ GFP library in Starvation Media
punctate22.960.76No -
C’ GFP library on the background of Pup2-DaMP

punctate -
C’ GFP library on the background of CCT mutant

punctate33.50441.12143No
